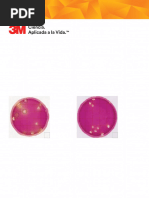

PLATE COUNT ÁGAR (PCA)
Finalidade:
Meio nutritivo destinado à contagem de microrganismos, ou manutenção de culturas de
bactérias.
Registro ANVISA:
10097010137
Apresentação:
530108 - PLATE COUNT-AGAR-FR 100mL
540171- PLATE COUNT-AGAR-TTC-20ML-PL 90X15-10PL
LB 172076
542566 - PLATE COUNT-AGAR-20mL-PL 90X15-PC 10PL
Rev. 11 – 04/2023
910270 -PLATE COUNT-AGAR-FR 100mL
1. INTRODUÇÃO Para ambas as composições, a fórmula pode ser ajustada e/ou
A Contagem Total de Aeróbios Mesófilos em placas, (Aerobic Plate suplementada, conforme necessidade, para cumprir os critérios de
Count), também denominada como Contagem Padrão em Placas, é desempenho.
o método mais utilizado como indicador geral de populações
bacterianas em alimentos, águas, entre outros. A Contagem Total 3. AMOSTRA
de Aeróbios Mesófilos não diferencia tipos de bactérias, sendo a- Tipos de amostras
utilizada para se obter informações gerais sobre a qualidade de - O Plate Count Agar é usado para obter contagens microbianas do
produtos, práticas de manufatura, matérias primas utilizadas, leite e dos produtos lácteos, alimentos, águas e de outros materiais
condições de processamento, manipulação e vida de prateleira. de importância sanitária.
O acréscimo do TTC (Cloreto de Tetrafenil-tetrazólio) permite que - O laboratório deve estabelecer critérios de coleta, rejeição e
as colônias que eventualmente se desenvolvam no meio corem em conservação das amostras, conforme sua política da qualidade.
tonalidade vermelha, facilitando assim sua visualização. -Sempre considerar as necessidades específicas dos
Este meio é recomendado para contagem de Aeróbios Mesófilos microrganismos alvos das análises, microrganismos com
pelo método de plaqueamento em superfície (spread plate) e necessidades especiais (suplementos específicos ou ambiente
plaqueamento em profundidade (pourplate). controlados) podem não apresentar crescimento adequado se
O plaqueamento em superfície é considerado vantajoso, pois não semeados em meio de cultura que não apresente os requisitos
expõe os microrganismos ao calor do meio fundido, permite a mínimos.
visualização de características morfológicas e diferenciais de
colônias. Sua principal desvantagem é que o volume inoculado é 4. INFORMAÇÕES GERAIS DO PRODUTO
limitado à capacidade de absorção de líquido pelo meio de cultura, a- Armazenamento e estabilidade
que não permite a inoculação de mais do que 0,5mL por placa. O Para fins de transporte, o produto pode permanecer em temperatura
procedimento padrão é a inoculação de 0,1mL/placa de cada ambiente por até 72h. No laboratório, as placas devem ser
diluição, com limite de detecção de 100 UFC/g para produtos armazenadas conforme tabela abaixo, condições em que se
sólidos ou 10 UFC/mL para produtos líquidos. mantém estáveis até a data de vencimento expressa em rótulo,
O plaqueamento em profundidade tem limite de detecção de 10 desde que isento de contaminação de qualquer natureza. O uso de
UFC/g para produtos sólidos ou 1 UFC/ml para produtos líquidos. refrigerador tipo frost-free não é recomendado para meios de cultura
Esse procedimento pode ser adaptado, se necessário, para limite de devido ao efeito desidratante deste tipo de equipamento.
detecção de 1 UFC/g para produtos sólidos.
O PCA é formulado de acordo com a Associação Americana de Temperatura de
Apresentação
Saúde Pública (APHA), onde possui em sua formulação digestão armazenamento
enzimática de caseína que fornece aminoácidos e outras 540171 e 542566 (placas 90x15) 2 a 25ºC
substâncias nitrogenadas complexas que são necessárias para o 530108 e 910270 (frasco) Temp. ambiente
crescimento microbiano. O extrato de levedura fornece,
principalmente, o complexo de vitaminas B e a dextrose é uma fonte Considerando que este produto é gelatinoso e sua composição
de energia. O TTC é reduzido para o formazan insolúvel dentro da pode apresentar até 80% de água, ao sofrer variações de
célula bacteriana produzindo colônias vermelhas. temperatura (quente-frio ou frio-quente) todo meio de cultura pode
gerar condensação, de pouca a muita, acumulando água na placa.
2. COMPOSIÇÃO Recomenda-se guardar as placas com os meios de cultura virados
para cima e, quando necessário, desprezar a água acumulada e
Códigos: 530108, 542566 e 910270 deixar o meio de cultura estabilizar a temperatura antes de sua
Formulação Concentração/L utilização.
Digestão Pancreática de Caseína 5,0g Conforme descrito em literatura, o laboratório deve retirar da
Extrato de levedura 2,5g refrigeração apenas a quantidade de produto que deverá ser
Dextrose 1,0g utilizada em sua rotina e deixar estabilizar a temperatura. Como
Ágar 15,0g
alternativa o laboratório também pode utilizar um dos procedimentos
abaixo:
Água deionizada 1L
- Secar a água condensada em temperatura ambiente, antes de sua
utilização.
Código: 540171 - Incubar as placas em estufa (±37ºC), antes da sua utilização, para
Formulação Concentração/L redução do tempo de secagem ou estabilização.
Digestão Pancreática de Caseína 5,0g - Secar as placas com as tampas entreabertas em fluxo laminar,
Extrato de levedura 2,5g antes da sua utilização, para redução do tempo de secagem ou
Dextrose 1,0g estabilização.
Cloreto de Tetrafenil-tetrazólio 0,05g A repetição do processo de refrigeração/estabilização não é
Ágar 15,0g recomendada, a constante troca de temperatura pode levar a
Água deionizada 1L
desidratação do meio, expor o produto a contaminações ou gerar
um acúmulo de água excessivo.
www.laborclin.com.br 01
�PLATE COUNT ÁGAR LB 172076
Rev. 11 – 04/2023
A água acumulada por condensação, ocasionada por alguma h- Incubar as placas em estufa bacteriológica de acordo com a
variação de temperatura, não influência no desempenho do produto, técnica estabelecida pelo laboratório;
desde que este não apresente ressecamento ou diminuição de i- Após a incubação, realizar a avaliação do crescimento e proceder
espessura. à contagem de colônias conforme técnica adequada.
Devido à presença de substratos sensíveis, recomenda-se manter o
produto protegido de incidência direta de luz (natural ou artificial) e 7. RESULTADOS
evitar grandes variações de temperatura até a utilização. Realizar a contagem das colônias e calcular o resultado conforme o
método de análise seguido pelo laboratório, ou seguir as
b- Precauções e cuidados especiais orientações descritas abaixo:
- O produto é destinado apenas para o uso in vitro;
- Seu uso é restrito por profissionais; a- Proceder a contagem das colônias;
- Mesmo se tratando de produto livre de agentes infecciosos, b- Calcular o resultado conforme a formula:
recomenda-se tratar este produto como potencialmente infeccioso,
observando o uso de equipamentos de proteção individual e UFC/mL ou UFC/g = M x (1/ V) x D
coletivo;
- Não inalar ou ingerir; Onde:
- Não utilizar placas com sinais de contaminação, ressecamento ou M: Média das colônias obtidas em placas da mesma diluição;
com alterações de cor ou espessura; V: Volume inoculado nas placas;
- Não usar materiais com o prazo de validade expirado, ou que D: Inverso da diluição inoculada, referente às placas onde foram
apresentem selo de qualidade rompido ou violado; obtidas as contagens.
- Recomenda-se a leitura da diretriz aprovada para “Proteção de
Trabalhadores de Laboratório e Infecções Obtidas no Trabalho - c- Expressar o resultado UFC/mL ou UFC/g.
CLSI® M29-A” para o manuseio seguro;
- Para acondicionamento e descarte do material utilizado, autoclavar 8. LIMITAÇÕES DO MÉTODO
a 121ºC por 20 minutos. Recomendamos o uso dos sacos Detrilab. (Riscos Residuais Identificados conforme RDC 36/2015)
- Os procedimentos de manuseio referentes ao processamento e Os resultados falsamente positivos ou negativos podem ocorrer,
manuseio para o descarte deverá estar de acordo com a RDC 222, com maior frequência, nas seguintes situações:
DE 28 DE MARÇO DE 2018 que dispõe sobre o Regulamento -O Plate Count Agar para plaqueamento em profundidade apresenta
Técnico para o gerenciamento de resíduos de serviços de saúde. algumas limitações, a principal delas sendo a necessidade de fusão
do meio de cultura antes do uso. Não podendo ser reaquecidos
5. MATERIAIS E EQUIPAMENTOS NECESSÁRIOS (porém não mais que uma vez.
fornecidos) - A única restrição feita ao TTC é que esta substância causa um
- Estufa bacteriológica; crescimento mais lento para microrganismos Gram-positivos (como
- Pipetas/ ponteiras estéreis; estafilococos e estreptococos).
- Alça bacteriológica (ou outros aparatos para dispensação de - Tempo longo entre a semeadura da amostra e análise.
amostra); - Incubação em temperatura inadequada.
- Banho-maria; - Sobrecarga de inóculo ou falta de inóculo.
- Bico de Bunsen. - Interpretação equivocada de resultados.
- Técnica de assepsia inadequada.
6. PROCEDIMENTO TÉCNICO - Tempo excessivo ou insuficiente de incubação. Tempo excessivo
de incubação fornece resultados falsamente positivos e tempo
6.1 Técnica em Superfície (Spread plate) insuficiente fornece resultados falsamente negativos.
a- Retirar o pacote de placas da geladeira e separar as placas a - Utilização de material vencido, contaminado ou em condições
serem utilizadas, retornando o pacote à geladeira; inadequadas.
b- Colocar as placas em estufa bacteriológica entre 35-37ºC pelo - Contaminação cruzada por uso de acessórios não esterilizados
tempo necessário para adquirirem esta temperatura; corretamente ou ambiente não asséptico.
c- Realizar a diluição da amostra conforme procedimento do - Utilização de meios de cultura com aparência alterada.
laboratório; - Não aguardar para que os materiais atinjam a temperatura
d- Inocular as amostras nas placas de acordo com a técnica ambiente no momento do uso.
estabelecida pelo laboratório; - Erro na conservação do produto pode ocasionar desidratação do
e- Incubar as placas em estufa bacteriológica de acordo com a meio e alteração das propriedades dos componentes.
técnica estabelecida pelo laboratório;
f- Após a incubação, realizar a avaliação do crescimento e proceder 9. CONTROLE DE QUALIDADE
à contagem de colônias conforme técnica adequada. - Materiais necessários
Nota 1: No ágar com TTC, para gram positivos recomenda-se Cepas padrão: ATCC®(American Type Culture Collection) ou
incubar por 48 horas pelo retardo de crescimento causado por este derivadas).
componente;
Nota 2: No meio com TTC as colônias coram em tonalidade - Controle de qualidade recomendado:
vermelha. Parâmetros Resultado esperado
Incubação
6.2 Técnica em profundidade (Pourplate) Produtividade quantitativa - PR≥0,7 - Contagem obtida em
30-35°C por
E. coli ATCC 25922 comparação ao ágar TSA*
a- Fundir o meio de cultura; 72h
b- Resfriar o meio de cultura fundido a 44-46ºC; Incubação
Produtividade quantitativa - PR≥0,7 - Contagem obtida em
c- Realizar a diluição da amostra conforme procedimento do 30-35°C por
S. aureus ATCC 25923 comparação ao ágar TSA*
laboratório; 72h
Meio sólido levemente opaco, com coloração
d- Inocular as amostras em placas de petri estéreis, de acordo com
Meio não inoclulado bege a levemente amarelada, livre de
a técnica estabelecida pelo laboratório; precipitados ou partículas visíveis.
e- Verter nas placas inoculadas o meio de cultura previamente * Inóculo aproximado de 100 UFC
fundido e resfriado a 44-46ºC, verter aproximadamente 15 mL de Inóculo aproximado de <100 UFC (para testes no cód.910270)
meio de cultura ou o volume indicado pelo método seguido pelo
laboratório; - Periodicidade
f-Misturar o inóculo com o meio de cultura movimentando Testar a cada novo lote recebido ou em periodicidade estabelecida
suavemente as placas, em superfície plana, em movimentos em pelo próprio laboratório.
forma de oito ou em movimentos circulares, nos sentidos horário e
anti-horário; - Análise dos resultados
g- Permitir que o meio esfrie e solidifique;
www.laborclin.com.br 02
�PLATE COUNT ÁGAR LB 172076
Rev. 11 – 04/2023
As cepas padrão inoculadas no material devem apresentar
características de crescimento esperado. Caso se constate algum
problema referente a não recuperação do inóculo de cepas controle,
os resultados de amostras não devem ser liberados até que as
causas tenham sido apuradas devidamente e os problemas
constatados sanados.
10. GARANTIA DA QUALIDADE
A Laborclin obedece ao disposto na Lei 8.078/90 - Código de
Defesa do Consumidor. Para que o produto apresente seu melhor
desempenho, é necessário:
- que o usuário conheça e siga rigorosamente o presente
procedimento técnico;
- que os materiais estejam sendo armazenados em condições
adequadas;
- que os equipamentos e demais acessórios necessários estejam
em boas condições de uso, manutenção e limpeza.
Antes de ser liberado para venda, cada lote do produto é submetido
a testes específicos, que são repetidos periodicamente até a data
de vencimento expressa em rótulo. Os certificados de análise de
cada lote podem ser obtidos junto ao site www.laborclin.com.br. Em
caso de dúvidas ou outras informações, contatar o SAC - Serviço de
Assessoria ao Cliente através do telefone 0800-0410027 ou pelo e-
mail sac@laborclin.com.br. Quaisquer problemas que inviabilizem
uma boa resposta do produto, que tenham ocorrido
comprovadamente por falha da Laborclin serão resolvidos sem ônus
ao cliente, conforme o disposto em lei.
11. REFERÊNCIAS BIBLIOGRÁFICAS
1. APHA. Compendium of Methods for the Microbiological
Examination of Foods.5th ed. American Public Health Association,
Washington, D.C., 2015.
2. APHA. Standard methods of water and wastewater.23nd. Ed.
Washington, 2017.
3.CODEX ALIMENTARIUS. Code of hygienic practice for collecting,
processing and marketing of natural mineral waters (CAC/RCP 33-
195, Revisão 2011). Rome: FAO, 2011. FAO/WHO Food Standards
Program.
4. Difco Manual, 2nd ed., 2009.
5. ISO 4833-1. Microbiology of the food chain – Horizontal method
for the enumeration of microorganisms – Part 1: Colony count at
30°C by the pour plate technique. The International Organization for
Standardization, 1st edition, 2013.
6. ISO 4833-2. Microbiology of the food chain – Horizontal method
for the enumeration of microorganisms – Part 2: Colony count at
30°C by the surface plate technique. The International Organization
for Standardization, 1st edition, 2013, Corrigendum 1, 2014.
7. ISO 11133. Microbiology of food, animal feed and water –
Preparation, production, storage and performance testing of culture
media.1rd ed. The International Organization for Standardization,
2014.
8.Portaria Consolidada n°5, de 8 de setembro de 2017. Anexo XX.
9. SILVA, de Neusely; et al. Manual de Métodos de Análise
Microbiológica de Alimentos e Água, 5ª ed. São Paulo: Blucher,
2017.
Laborclin Produtos para Laboratórios Ltda
CNPJ 76.619.113/0001-31
Insc. Estadual 1370012926
Rua Casimiro de Abreu, 521
Pinhais/PR CEP 83.321-210
Telefone 041 36619000
www.laborclin.com.br
Responsável Técnico:
Daniela Fialho – CRF/PR-37492
Serviço de Assessoria ao Cliente
SAC 0800-0410027
sac@laborclin.com.br
www.laborclin.com.br 03